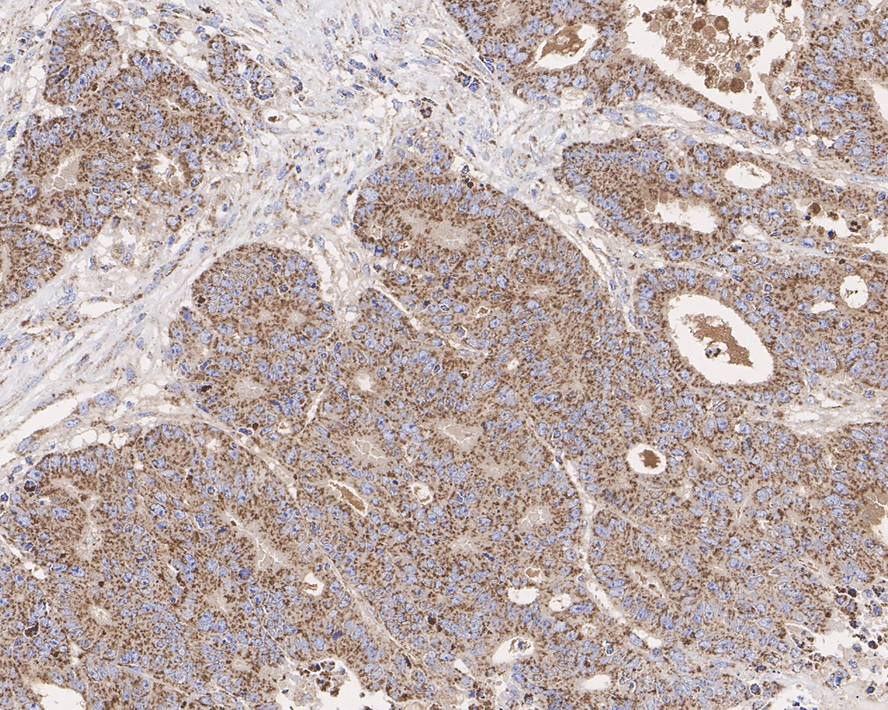
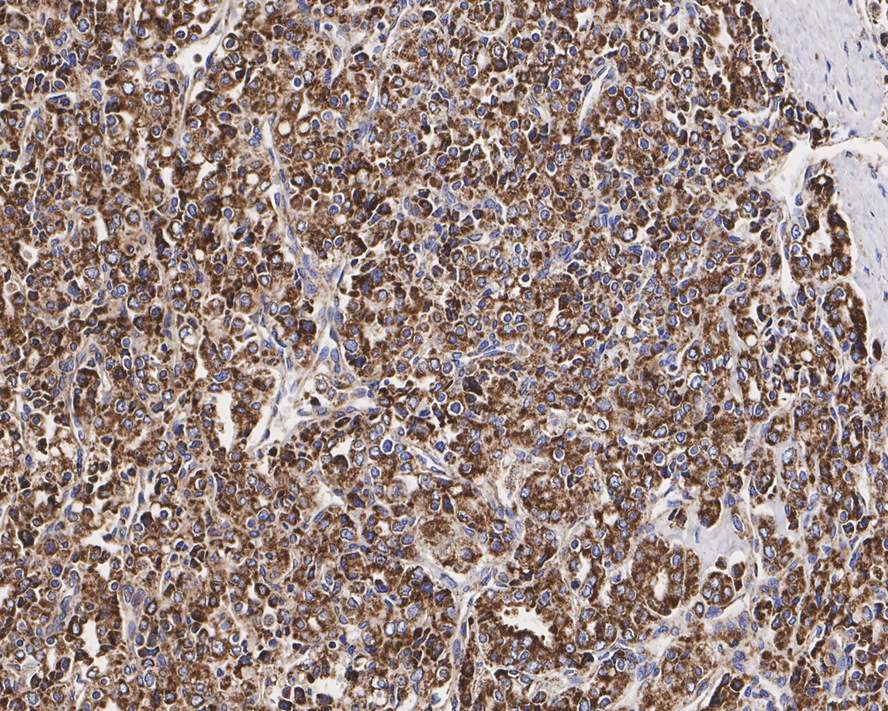
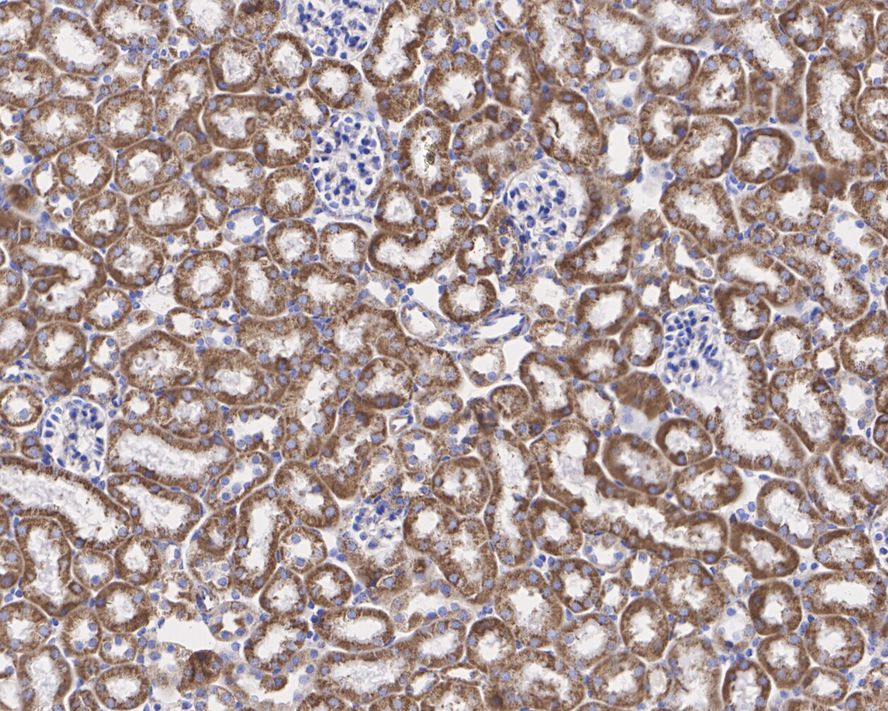

Catalog# HA721503
CLPP Recombinant Rabbit Monoclonal Antibody [JE40-00]
Application
-
WB
-
IHC-P
-
IF-Cell
-
FC
Reactivity
-
Human
-
Mouse
-
Rat